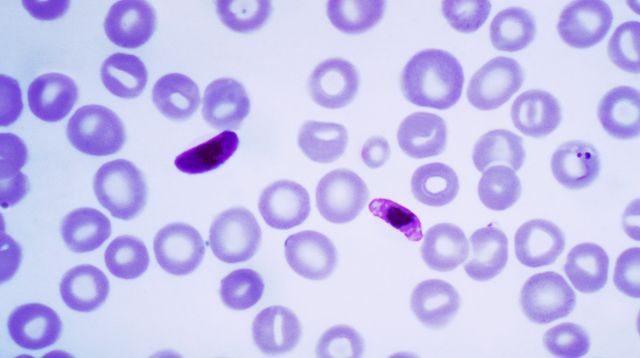

Updated November 2025
“Education is the most powerful tool that you can use to change the world.”
-Nelson Mandela
ISODP Education Working Group would like to thank the organizations that freely provide their local eductional material and make it available to donation professionals around the world to improve professionalism in this sector.
DISCLAIMER
The information provided on this site is for educational purposes only. The content is a compilation of the work produced by experts from many countries, taking into account their own local legislative and medical criteria, and whilst the information provided may be aligned to best practice in those countries, it may not be suitable or appropriate for reproduction or training in other countries. It is merely an adjunct to the learnings of health professionals in the donation sector. Quality and accuracy of contents remains the responsibility of the authors of the educational activity and may not represent the views of ISODP.
The information provided on this site is for educational purposes only. The content is a compilation of the work produced by experts from many countries, taking into account their own local legislative and medical criteria, and whilst the information provided may be aligned to best practice in those countries, it may not be suitable or appropriate for reproduction or training in other countries. It is merely an adjunct to the learnings of health professionals in the donation sector. Quality and accuracy of contents remains the responsibility of the authors of the educational activity and may not represent the views of ISODP.
Table of Contents
- Organ Donor Assessment
- Donor Derived Disease Transmission
- Diagnosis of Death by Neurological Criteria
- Donor Management / Optimisation
- Family Approach for Organ Donation
- Organ Retrieval and Preservation Techniques
- Organ Packaging and Labelling of Organs in the Operating Theatre
- Organ Allocation for Transplantation
- Donation after Circulatory Death - Uncontrolled
- Donation after Circulatory Death - Controlled
- Normothermic Regional Perfusion (NRP)
- Organ Donation following Euthanasia / Medical Assistance in Dying (MAiD)
- Organization of an Organ Donation Coordination Office
- Organizational Models
- Eye and Tissue Donation
- School Level Education – Primary School
Organ Donor Assessment
TSANZ Clinical Guidelines


The Transplantation Society of Australia and New Zealand provides Clinical Guidelines for Organ Transplantation from Deceased Donors. They are also accessible on mobile and tablet.
Donor Derived Disease Transmission

Diagnosis of Death by Neurological Criteria
Donor Management / Optimisation
Donor Management - Canada
Family Approach for Organ Donation
Organ Retrieval and Preservation Techniques
Organ Packaging and Labelling of Organs in the Operating Theatre
Organ Allocation for Transplantation
Donation after Circulatory Death - Uncontrolled
Donation after Circulatory Death - Controlled
Normothermic Regional Perfusion (NRP)
Organ Donation following Euthanasia / Medical Assistance in Dying (MAiD)
Organization of an Organ Donation Coordination Office
Organizational Models
Eye and Tissue Donation
School Level Education – Primary School
Social
Contact
Address
International Society for Organ
Donation Professionals
c/o The Transplantation Society
740 Notre-Dame Ouest
Suite 1245
Montréal, QC, H3C 3X6
Canada






















